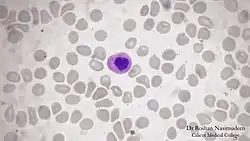

Granulócito neutrófilo
Granulócito neutrófilo
| |
|---|---|
![]() | |
| Subclasse de | granulócito |
| Desenvolve-se a partir de | band cell |
| Cell Ontology | CL_0000775 |
| MeSH | D009504 |
| Foundational Model of Anatomy | 62860 |
Os neutrófilos são células sanguíneas leucocitárias que fazem parte essencial do sistema imune inato. Pertencem à classe dos granulócitos, junto aos eosinófilos e basófilos, pois apresentam núcleos irregulares e contêm grânulos citoplasmáticos específicos.[1] Estão envolvidos na defesa contra bactérias e fungos. Os neutrófilos possuem receptores na sua superfície, como os receptores de proteínas do complemento, receptores do fragmento Fc das imunoglobulinas e moléculas de adesão.
Morfologia Celular
Quando visualizado no sangue periférico humano através de um esfregaço sanguíneo e corado, o neutrófilo apresenta-se como uma célula de diâmetro entre 10-14µm (micrômetros). São células arredondadas com núcleo polilobulado que, geralmente, apresenta entre dois a cinco lóbulos ligados por um fino filamento nuclear. Seu citoplasma é abundante e possui grânulos dispersos. Os seus grânulos são divididos em primários ou azurófilos e secundários ou específicos.[1]
Os grânulos primários aparecem no estágio promielócito. Os secundários são encontrados no estágio mielocítico e predominantes no neutrófilo maduro. Quando a célula jovem ainda não está segmentada em lobulações é chamada de neutrófilo com núcleo em bastonete. Os grânulos primários (lisossomos) contêm enzimas e polipeptídeos que participam da digestão celular. Já os grânulos secundários, atuam principalmente na proteção da célula e combate a patógenos.[1]
Função
Fagocitose

Neutrófilos são fagócitos capazes de emitirem prolongamentos citoplasmáticos que envolvem partículas estranhas, que são digeridas por enzimas presentes nos vacúolos celulares. Após a entrada da partícula, forma-se o fagossoma onde os microrganismos serão mortos pela liberação de enzimas hidrolíticas e de espécies reativas de oxigênio. O consumo de oxigênio durante a reação de espécies de oxigênio é chamado de queima respiratória que nada tem a ver com respiração celular ou produção de energia.
A queima respiratória ou burst respiratório envolve a ativação da enzima NADPH oxidase na membrana do fagossoma, que produz grandes quantidades de superóxido, uma espécie reativa do oxigênio. O superóxido gera o peróxido de hidrogênio que é convertido em ácido hipocloroso (HClO) pela enzima mieloperoxidase. É o HClO que tem propriedades suficientes para matar a bactéria fagocitada.
Degranulação
Os neutrófilos eliminam o conteúdo dos seus três tipos de grânulos que contém propriedades antimicrobianas e ajudam no combate às infecções.
| Tipos de grânulos | Conteúdos |
| Grânulos específicos (ou "secundários") | Lactoferrina, Catelicidina, Fosfatase alcalina, Colagenase (gelatinase), Lisozima, Proteínas básicas antibacterianas, não enzimáticas, Lipocalina. |
| Grânulos azurófilos (ou "primários") | Mieloperoxidase, Proteína de aumento da permeabilidade/bactericida (BPI), Defensina, serina proteases, Fosfatase ácida, α- Manosidase, Arilsulfatase, β-Galactosidase, β-Glicosidase, Catepsina G, 5'-Nucleotidase, Elastase, Colagenase, Mieloperoxidase, Lisozima, Proteínas antibacterianas catiônicas. |
| Grânulos terciários | Catepsina, Gelatinase. |
Formação de NETs
Em 2004 foi descoberta uma terceira estratégia dos neutrófilos para conter e matar patógenos, a emissão de armadilhas extracelulares dos neutrófilos (NETs). Esse mecanismo consiste na emissão de rede pelo granulócito contendo enzimas dos grânulos citoplasmáticos e o DNA da célula. Essa rede, então, é capaz de aprisionar e eliminar agentes infecciosos.[2]
Quantidade
Os neutrófilos são os leucócitos mais abundantes (60 a 70%) na maioria dos mamíferos.[3] Quando há um aumento no número de neutrófilos circulantes é chamado de neutrofilia e quando há diminuição neutropenia.[4]
Vida Útil
Os neutrófilos, têm uma expectativa de vida curta, de 5 a 90 horas, na corrente sanguínea.[5] Após sua ativação e migração para tecido (diapedese) o neutrófilo sobrevive de 1 a 2 dias. Os neutrófilos são muito mais numerosos que os monócitos ou macrófagos que tem expectativa de vida mais longa. Alguns especialistas acreditam que a curta duração dos neutrófilos seja uma adaptação evolutiva. O curto tempo de vida dos neutrófilos minimiza a propagação de patógenos intracelulares, porque quanto mais tempo esses parasitas passam fora de uma célula hospedeira, maior a probabilidade de serem destruídos por algum componente das defesas do organismo. Além disso, como os produtos antimicrobianos de neutrófilos também podem danificar os tecidos do hospedeiro, sua curta duração limita o dano ao hospedeiro durante a inflamação.[6]
Referências
- ↑ a b c d Junqueira, Luiz Carlos Uchôa, 1920- (2003). Basic histology. [S.l.]: Lange Medical Books McGraw-Hill. ISBN 0071378294. OCLC 606266970
- ↑ Brinkmann, V. (5 de março de 2004). «Neutrophil Extracellular Traps Kill Bacteria». Science. 303 (5663): 1532–1535. ISSN 0036-8075. doi:10.1126/science.1092385
- ↑ Ermert, David. Niemiec, Maria J. Röhm, Marc. Glenthøj, Andreas. Borregaard, Niels. Urban, Constantin F. Candida albicans escapes from mouse neutrophils. [S.l.: s.n.] OCLC 1053698163
- ↑ Dorland, W. A. (novembro de 1930). «American Pocket Medical Dictionary». Southern Medical Journal. 23 (11). 1044 páginas. ISSN 0038-4348. doi:10.1097/00007611-193011000-00027
- ↑ Tak, Tamar; Tesselaar, Kiki; Pillay, Janesh; Borghans, José A. M.; Koenderman, Leo (outubro de 2013). «Whatˈs your age again? Determination of human neutrophil half-lives revisited». Journal of Leukocyte Biology. 94 (4): 595–601. ISSN 0741-5400. doi:10.1189/jlb.1112571
- ↑ Stevens, Alan (2002). Wheater's basic histopathology: a colour atlas and text. [S.l.]: Churchill Livingstone. ISBN 0443070016. OCLC 901159691